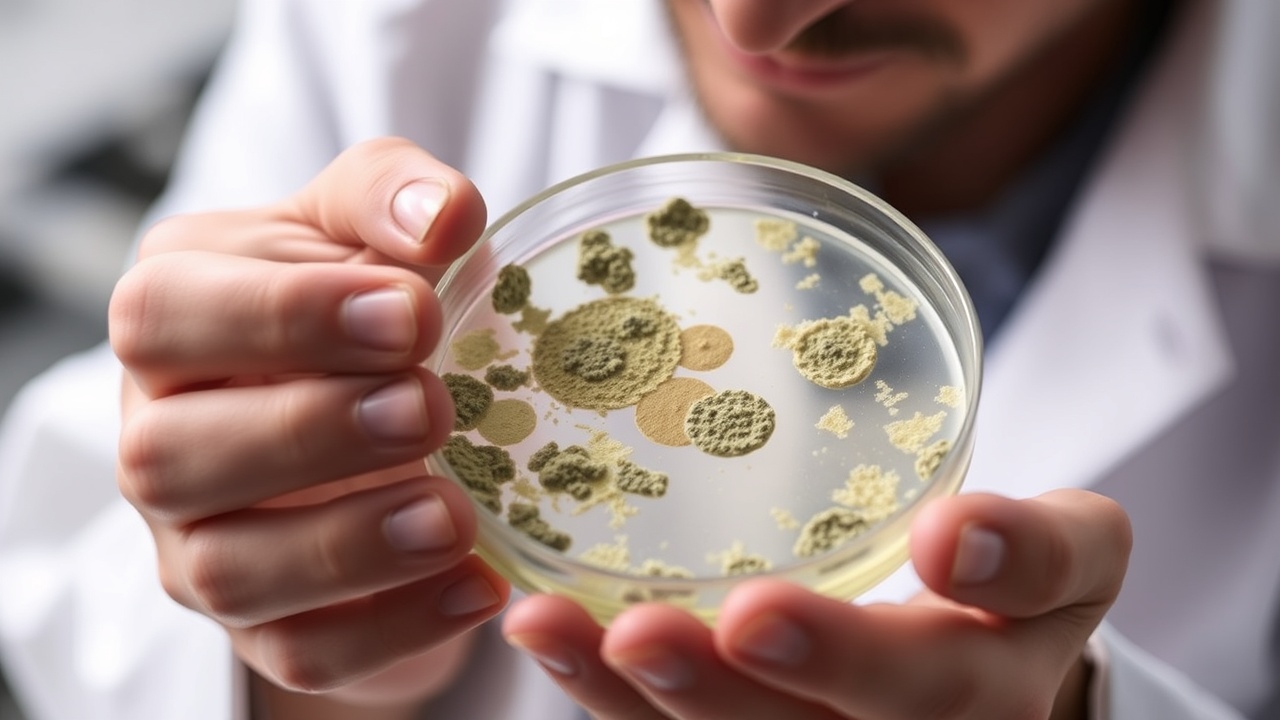

Mold can be a serious problem in many environments, especially in areas prone to moisture. If you’re dealing with mold issues, you may be wondering, does Shockwave kill mold? In this article, we will explore the capabilities of Fiberlock Shockwave, an EPA-registered disinfectant designed specifically for mold remediation. Shockwave is formulated to penetrate and eliminate mold spores, providing effective treatment for contaminated surfaces. Its unique properties allow it to not only kill existing mold but also prevent future growth when used correctly. It is essential to follow the manufacturer’s guidelines for application to ensure optimal results. Additionally, using Shockwave in conjunction with proper ventilation and moisture control can significantly enhance its effectiveness in mold remediation efforts. Understanding how to utilize Shockwave effectively can help you manage and eliminate mold problems in your environment, promoting a healthier living space.
What is Shockwave Disinfectant And Cleaner?
Shockwave is a hospital-grade disinfectant and cleaner that is effective for treating mold and mildew. It is particularly valuable in the abatement and remediation industry due to its ability to kill more than 130 organisms, including Aspergillus niger and Penicillium spinulosum. The product is available in a 1-gallon concentrate form, which can be diluted to create up to 64 gallons of usable product.
Shockwave’s Effectiveness Against Mold
One of the most significant advantages of using Fiberlock Shockwave is its effectiveness in killing mold on both porous and non-porous surfaces. This makes it an ideal choice for water damage restoration and mold remediation projects. When applied correctly, Shockwave can sanitize and disinfect surfaces that are subject to microbial contamination.
How Does Shockwave Works?
Shockwave is designed to penetrate and disinfect various surfaces, effectively eliminating mold spores and preventing future growth. Its EPA-registered status ensures that it meets stringent safety and efficacy standards. When using Shockwave, it is crucial to follow the manufacturer’s instructions for dilution and application to achieve the best results. The product works by targeting the cell structure of mold spores, disrupting their ability to reproduce and thrive. This not only eliminates existing mold but also creates an environment that is less conducive to future mold growth. Users should apply Shockwave in areas prone to moisture, where mold is likely to develop, such as bathrooms, kitchens, and basements. Regular application can significantly reduce the risk of mold re-establishment. Furthermore, it’s advisable to wear protective gear, such as gloves and masks, during application to ensure safety from any potential irritants. Overall, Shockwave is a powerful ally in the fight against mold, providing both immediate and long-term protection.
Application Areas for Shockwave
Shockwave can be used in a variety of settings, including:
- Residential homes affected by water damage
- Commercial properties undergoing mold remediation
- Healthcare facilities requiring strict sanitation protocols
- Any surfaces prone to microbial contamination
Benefits of Using Fiberlock Shockwave
Using Fiberlock Shockwave disinfectant offers numerous benefits:
- Hospital-grade effectiveness: Shockwave is a strong enough cleaner to handle serious mold problems.
- All-in-one product: Designed for mold remediation contractors, it serves as both a sanitizer and cleaner.
- Versatile application: Effective on both porous and non-porous materials.
- Proven kill claims: Its ability to kill a wide range of organisms makes it a reliable choice.
Conclusion
In conclusion, Shockwave is an effective solution for those dealing with mold issues. Its status as an EPA-registered disinfectant and its proven ability to kill mold makes it a trusted choice for both residential and commercial applications. If you’re looking for a reliable product for mold remediation, consider Fiberlock Shockwave for your next project.
For more information and to purchase, visit Fiberlock Shockwave on Amazon.